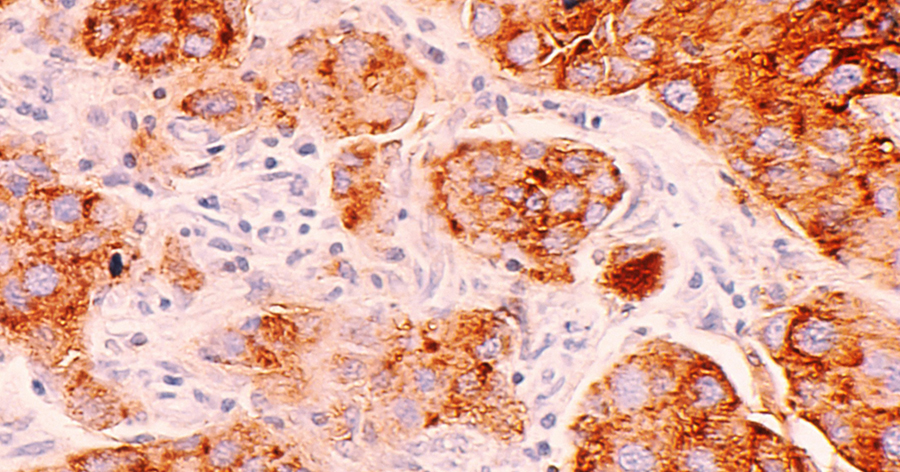

Tervetuloa Karkkipäivän joulukalenteriin vuodelle 2025. ☺️ 🎄

Tänä vuonna joulukalenterin teema on:
antioksidantit ihonhoidossa
Esittelen jokaisen päivän luukussa iholle hyödyllisen antioksidantin, ja bonuksena jokaisessa luukussa on myös arvonta, jossa voi voittaa kyseistä antioksidanttia sisältävän ihonhoitotuotteen. 😍
*

Päivän antioksidantti: KROKIINI
Jouluaaton luukussa tapaamme ylellisen antioksidantin; maustesahramin krokiinin.
Maustesahrami sisältää monia bioaktiivisia yhdisteitä kuten krokiineja, safranaalia, flavonoideja ja pikrokrokiiniia. Näistä merkittävin on krokiini, joka on mielenkiintoinen ja harvinaislaatuinen antioksidantti: se on vesiliukoinen karotenoidi (useimmat muut karotenoidit kuten beetakroteeni, lykopeeni ja astaksantiini ovat öljyliukoisia). Krokiini tuo sahrami-mausteeseen sen kirkkaankeltaisen tai kirkkaanpunaisen värin.
Krokiini on yksi voimakkaimpia antioksidantteja; moninkertaisesti tehokkaampi sieppaamaan vapaita radikaaleja ja reaktiivisia happilajeja (ROS) kuin C- ja E-vitamiini.
Krokiinia esiintyy maustesahramissa, gardeniassa sekä syyssyrikässä.

Krokiinin ihohyötyjä:
1. Vahva antioksidanttisuoja. Krokiini suojaa ihoa oksidatiiviselta stressiltä.
2. Suojaa ihoa valovanheneniselta. Krokiini neutraloi tehokkaasti UV-säteilyn ja sinisen valon (HEV-valo) aiheuttamaa oksidatiivista stressiä. Se toimii ikään kuin sisäisenä suodattimena, joka estää valon aiheuttamia vaurioita solutasolla. Joidenkin tutkimusten mukaan krokiinit voivat suojata ihosoluja erityisesti UVB-säteiden aikaansaamilta vaurioilta ja vähentää auringonpolttaman oireita.
3. Rauhoittaa tulehdusta ja punoitusta. Krokiinilla on voimakkaita anti-inflammatorisia ominaisuuksia ja on erinomainen ainesosa herkälle, stressaantuneelle tai akneen taipuvaiselle iholle.
4. Kirkastaa ihoa ja lievittää hyperpigmentaatiota. Krokiini estää tyrosinaasi-entsyymin toimintaa, mikä vähentää melaniinin ylituotantoa. Krokiini auttaa häivyttämään tummia läiskiä ja tekee ihon sävystä tasaisemman ja kirkkaamman.
5. Suojaa kollageenia. Krokiini estää kollagenaasi-entsyymejä, jotka hajottavat ihon rakenneproteiineja. Tämä auttaa säilyttämään ihon kimmoisuutta.
Kosmetiikassa krokiinia ei käytetä eristettynä, vaan se tulee kasviuutteiden kuten sahramin (Crocus Sativus Stigma Extract) tai syyssyrikän (Buddleja Officinalis Flower Extract) mukana.

Tuotteen on lahjoittanut: Korres
Arvonta sulkeutunut. Luukun voittaja on nimimerkki hanneh.
Jouluaaton luukku tarjoaa kalenterin ylellisimmän tuotteen: kallisarvoisen Golden Crocus -seerumin. Tämä on Korresin ultimaattinen pro age -seerumi, jota kreikkalaiset himoitsevat brändin kotimaassa. ✨ Sahramieliksiiri on Kreikassa tunnettu ja maineikas tuote.
Golden Crocus -seerumi saa nimensä sahramin latinankielisestä nimestä Crocus Sativus. Sahraminkukka tunnetaan myös nimellä krookus. Tämä upea ikääntymismuutoksia hidastava seerumi sisältää sahramiuutteen ohella peptidejä, ultra-pienikokoista hyaluronihappoa, kaurauutetta, kuusamauutetta sekä Neodermyl® -nimisen aminohappoyhdisteen, jonka on kliinisissä testeissä todettu stimuloivan fibroblastisoluja, mitä kautta se parantaa kollageenin ja elastiinin tuotantoa. Neodermyl® on incissä nimellä Copper Lysinate/Prolinate + Glycerin + Methylglucoside Phosphate (jos jotakuta tällainenkin nippelitieto kiinnostaa ☺️)
Golden Crocus -seerumi parantaa ihon kiinteyttä ja joustavuutta, vähentää juonteiden syntyä, lisää ihon heleyttä sekä tasoittaa ihon sävyä ja rakennetta.
🎄 Ihanaa joulua kaikille! 🧑🏻🎄

Päivän antioksidantti: APIGENIINI
Luukut lähestyvät loppuaan… ja tänään tapaamme antioksidantin nimeltä apigeniini. Apigeniiniä esiintyy runsaasti kamomillassa ja persiljassa ja pienempiä määriä esimerkiksi sellerissä, timjamissa, greipissä ja piparmintussa. Kosmetiikkaan apigeniini tulee tyypillisesti kamomillauutteessa.
Apigeniini on flavonoidien ryhmään kuuluva antioksidantti, tarkemmin flavoni. Sen tärkein vaikutus on rauhoittaa tulehdusta. Joku eilen kommentoi, että on mielenkiintoista, että niin moni kalenteriluukun antioksidantti rauhoittaa ihoa ja hillitsee tulehdusta. Tämä pitää paikkansa, ja juontaa siihen, että kalenterissa on paljon fenolisia yhdisteitä (joihin flavonoiditkin kuuluvat). Juuri fenoleilla on erittäin vahva anti-inflammatorinen vaikutus. 👩⚕️

Apigeniinin ihohyötyjä:
1. Rauhoittaa tulehdusta. Apigeniin vähentää tulehdusta monivaikutteisesti. Kamomilla sisältää muitakin tulehdusta rauhoittavia yhdisteitä kuten kamatsuleenia, alfa-bisabololia ja luteoliinia, joten ei ihmekään, että kamomillalla on pitkät perinteet lääkinnällisenä kasvina!
2. Antioksidanttinen suoja. Apigeniinillä on tässä kaksoisrooli; se toimii sekä vapaiden radikaalien sieppaajana että aktivoi ihon omia antioksidanttientsyymejä.
3. Kirkastaa ihoa. Joissain tutkimuksissa apigeniinillä on myös todettu tyrosinaasia hillitsevä vaikutus, joka on lievä, mutta pitkäkestoinen.
4. Tukee ihon paranemista. Apigeniini edistää keratinosyyttien järjestäytymistä ja vähentää oksidatiivista stressiä haavan ympärillä. Apigeniini tukee ihon normaalin läpäisyesteen palautumista ihovaurion jälkeen.
Huomaa, että kamomillan eteerinen öljy (Flower Oil) tai kamomillahydrolaatti (Flower Water) eivät sisällä apigeniinia, ainoastaan kamomillan kukkauutos (Flower Extract) voi sisältää apigeniiniä.
Tunnistat apigeniiniä sisältävän kamomilla-ainesosan incissä nimellä Chamomilla Recututita (tai) Anthemis Nobilis Flower Extract. Chamomilla Recutita on Saksan kamomilla eli kamomillasaunio, Anthemis Nobilis on Rooman kamomilla eli jalosauramo. Rooman kamomillan voi joskus bongata incistä myös nimellä Chamaemelum Nobile.

Tuotteen on lahjoittanut: Twistbe
Arvonta sulkeutunut. Luukun voittaja on nimimerkki Saya.
Täältä saapuu jälleen ihana herkän ihon hemmottelija..! Jasmine Flower Menopause Facial Cream on kehitetty rauhoittamaan hormonaalisista syistä stressaantunutta ihoa. (Mutta sinulla ei tarvitse olla premenopaussi tai menopaussi päällä hyötyäksesi tästä voiteesta..!)
Silkkisen kermainen Jasmine Flower -voide sisältää tarkoin valitun joukon kosteuttavia, ihoa vahvistavia ja rauhoittavia aktiiviaineita. On manteliöljyä, hunajaa, avokadoöljyä, kamomilla-, kaura- ja vihreän teen uutetta 😍, hyaluronihappoa, avokadoöljyä, kiwinsiemenöljyä, sheavoita…
Ylellisessä voidecocktailissa tuoksuu pehmeä jasmiininkukka. En itse yleensä pidä jasmiinista kun se on niin voimakas, mutta Antipodesin voiteessa jasmiinin tuoksu on ihastuttavan seesteinen ja kerrassaan viehättävä.
Jasmine Flower Menopause Facial Cream on kasvovoide sinulle, jonka iholla on ikääntymisen, hormonaalisten muutosten tai stressin mukanaan tuomia muutoksia; kuivuutta, punoittelua, juonteita ja reaktiivisuutta. Jasmiini-voide kosteuttaa, silottaa, rauhoittaa ja vahvistaa ihoa, palauttaen ihon hehkun ja kimmoisuuden.

Päivän antioksidantti: GLABRIDIINI
Tämän päiväisessä luukussa tapaamme yhden lakritsi-kasvin antioksidanteista: ihoa kirkastavan ja rauhoittavan glabridiinin. Glabridiinia saadaan lakritsin juuresta. Antioksidanttiluokitukseltaan se on flavonoidi.
Lakritsinjuuressa on useita muitakin iholle hyödyllisiä yhdisteitä kuten Licochalcone A:ta, glykyrritsiiniä ja likviritiiniä, mutta glabridiini on ihohyötyjensä puolesta tutkituin. Lakritsinjuuren antioksidanteilla on kokonaisuutena erityisesti ihoa kirkastava ja pigmenttiläiskiä hillitsevä sekä tulehdusta rauhoittava vaikutus. Lakritsinjuuriuute kuuluu lemppariainesosiini kosmetiikassa!

Kuvassa kuivatun lakritsinjuuren palasia.
Glabridiinin ihohyötyjä:
1.Vaalentaa pigmenttiläiskiä. Glabridiini tunnetaan kyvystään lievittää hyperpigmentaatiota ja tasoittaa ihon sävyä. Kuten eilisessä luukussa tavattu askorbiinihappo, glabridiini tekee sen estämällä tyrosinaasi-entsyymin toimintaa. Askorbiinihappoon verrattuna glabridiini on paljon hellävaraisempi. Itse asiassa lakritsia pidetään yhtenä turvallisimmista kirkastavista ainesosista myös raskauden aikana, toisin kuin esimerkiksi retinolia tai hydrokinonia.
2. Hillitsee tulehdusta. Glabridiinillä on voimakas tulehdusta lievittävä vaikutus. Lakritsinjuuri onkin suosittu ainesosa rosaceaa, aknen jälkeistä punoitusta tai auringon polttamaa ihoa hoitavissa tuotteissa.
3. Vahva antioksidanttisuoja. Kuten muutkin polyfenolit, glabridiini on vahva antioksidantti ja suojaa ihoa oksidatiiviselta stressiltä.
Glabridiini tulee kosmetiikkaan pääsääntöisesti lakritsinjuuriuutteen mukana, mutta joissain premium-sarjojen tuotteissa sitä on alettu käyttää myös eristettynä. Eristetty glabridiini on kallis raaka-aine. Lakritsinjuuriuutteen tunnistat incistä nimellä Glycyrrhiza Glabra Root Extract.

Tuotteen on lahjoittanut: Yin Your Skin
Arvonta sulkeutunut. Luukun voittaja on nimimerkki Venla.
Tänään tarjolla todella ylellinen tuote..! 👌 Aura-kasvoöljy pursuaa toinen toistaan upeampia aktiiviaineita, lakritsinjuuriuute on vain yksi niistä. Kirkastava, rauhoittava, uudistava ja ravitseva eliksiiri sisältää mm. purasruoho-, iltahelokki- ja tamanuöljyä, indigonlehtiuutetta sekä tyrnin ja ruusunmarjan hiilidioksidiuutoksia.
Lakritsinjuuri tulee Auraan osana kolmen kasvin muodostamaa yhdistettä: lakritsinjuuri, rohtosalkoruusu ja riisinlese. Patentoidulla menetelmällä uutettu yhdiste hillitsee tyrosinaasientsyymin aktiivisuutta, mikä ehkäisee liikapigmentaation syntymistä, kirkastaa ihoa, tasoittaa epätasaista sävyä sekä ehkäisee jo olemassa olevien läiskien tummentumista.
Auran kehittänyt Katja Kokko kertoi minulle tämän superkirkastavan yhdisteen todistetusta tehosta. Jo 0,5% kyseistä yhdistettä hillitsee tyrosinaasin toimintaa 88%. Tutkimuksessa lakritsinjuuren, rohtoslakoruusun ja riisinleseen yhdiste vähensi liikapigmentaatiota jopa 52% placebo-ryhmään verrattuna 56 päivän testijakson aikana.
Aura-kasvoöljy sopii erityisesti ikääntyvälle, kuivalle, ohuelle, samealle tai herkälle iholle, joka on taipuvainen punoitukseen ja pigmenttiläiskiin. Auran lämmin ja kukkainen tuoksu syntyy syntyy jasmiinin, magnolian ja porkkanansiemenen eteerisistä öljyistä.

Päivän antioksidantti: ASKORBIINIHAPPO eli puhdas C-vitamiini
Tänään koittaa vihdoin THE C-vitamiinin kalenteri-luukku! Tapaamme puhtaan C-vitamiinin itsensä, eli askorbiinihapon. Sama kaveri, jota syöt, kun ostat C-vitamiini-lisäravinteen kaupasta tai apteekista.
Askorbiinihappo on voimakkain ja biologisesti aktiivisin muoto C-vitamiinista. Aiemmissa luukuissa tutustuimme C-vitamiinin johdannaisiin, joilla niilläkin on erinomaisia antioksidanttisia vaikutuksia ja muita ihohyötyjä, mutta ne ovat teholtaan miedompia kuin askorbiinihappo. Puhdas askorbiinihappo briljeeraa ihonhoidossa kyvyllään stimuloida kollageenin tuotantoa; ominaisuus, joka on vain aniharvalla kosmetiikan ainesososalla. Askorbiinihappo on retinoidien ohella tutkituin sekä parhaiten tehonsa ikääntymismuutosten hidastamisessa osoittanut kosmetiikan raaka-aine. 🏆

Kuva: Allthingsnative / Creative Commons
C-vitamiini-triviaa: kun mietimme C-vitamiini-rikkaita kasviksia, olemme tottuneet ajattelemaan sitrushedelmiä, mutta tosiasiassa moni muu kasvis sisältää paljon enemmän C-vitamiinia kuin sitrushedelmät.
Ylivertainen C-vitamiinin lähde luonnossa on kakaduluumu (kuvassa), ja seuraavana tulevat acerola-kirsikka, ruusunmarja, chili, guava, keltainen paprika ja mustaherukka. Olisitko tiennyt, että jopa kukkakaalissa on enemmän C-vitamiinia kuin appelsiinissa..? 😳 (Lähde: Fineli).

Askorbiinihapon ihohyötyjä:
1. Tehostaa kollageenisynteesiä. Askorbiinihappo on välttämätön aine kollageenin muodostumisessa. Se toimii apuaineena entsyymeille, jotka rakentavat ja stabiloivat ihossa kollageenisäikeitä.
2. Kirkastaa ihoa ja lievittää tehokkaasti hyperpigmentaatiota. Askorbiinihappo estää tyrosinaasi-entsyymin tuotantoa ja voi myös keskeyttää melaniinisynteesin muuntamalla melaniinin esiasteen dopakinonin takaisin DOPAksi.
3.Tehokas antioksidanttisuoja. Suojaa ihoa vapaiden radikaalien aiheuttamalta hapettumisstressiltä.
4.Suojaa ihoa UV-säteilyn valovaurioilta. Erityisen tehokas tässä hommassa, kun sen yhdistää E-vitamiiniin ja ferulahappoon.
Askorbiinihapon haaste kosmetiikassa on sen epästabiilius. Se hapettuu herkästi etenkin vesimäisessä ympäristössä ja menettää tehonsa. Toinen haaste on erittäin matala pH, jonka askorbiinihappo vaatii kyetäkseen imeytymään ihoon. Tämä hyvin hapan pH tekee askorbiinihappo-tuotteesta potentiaalisesti ärsyttävän, eikä puhdasta askorbiinihappoa tästä syystä tyypillisesti suositella herkälle iholle.

Tunnistat askorbiinihapon incistä nimellä Ascorbic Acid tai L-Ascorbic Acid. Myös kakaduluumu-uute (Terminalia Ferdinandiana Fruit Extract) tuo ihoosi askorbiinihappoa, jos sitä on tuotteessa merkittävä pitoisuus. Kakaduluumu-uutteella on EU:n Cosing-tietokannassa virallisena funktiona antioksidanttisuuden ohella jopa ihoa vaalentava vaikutus!
Huom! Askorbiinihappo on vesiliukoinen yhdiste ja sijaitsee marjojen ja hedelmien hedelmälihassa, ei siemenissä. Usein näkee väitteitä, että esimerkiksi ruusunmarja- tai tyrniöljy (Seed Oil) sisältävät C-vitamiinia, mutta vain kyseisten marjojen hedelmäuute (Fruit Extract) sisältää C-vitamiinia.

Tuotteen on lahjoittanut: House Of Organic
Arvonta sulkeutunut. Luukun voittaja on nimimerkki Miia.
UPEA kaksifaasinen seerumi, ja PARAS tuntemani puhdasta C-vitamiinia sisältävä seerumi. 🤩 Askorbiinihapon stabiilius-haasteet on tässä tuotteessa ratkaistu laittamalla C-vitamiini vedettömään, öljypohjaiseen seerumiosioon (kumpikin faasi on omassa säiliössään), ja seerumin vesiliukoiset aktiiviaineet kuten ruusuvesi, glyseroli sekä puolukka- ja lakkauute yhdistyvät C-vitamiiniin vasta kämmenellä, kun pumppaat seerumia ulos pullosta. Nerokasta!
Joikin seerumi sisältää 15% askorbiinihappoa, mikä tekee siitä erittäin tehokkaan. Seerumissa on asiaankuuluva hapan pH, mikä tekee C-vitamiinista hyvin imeytyvän. Huomaa, ettei Illuminating Double Serum alhaisen pH:nsa ja korkean askorbiinihappo-pitoisuutensa vuoksi välttämättä sovi herkälle ja hauraalle iholle.
Tämä seerumi kirkastaa ihoa ja aktivoi kollageenin tuotantoa tehokkaasti, samalla kun se kosteuttaa ihoa kokonaisvaltaisesti tuoden ihoon sekä vesi- että lipidikosteutta. Kerrassaan upea pro-age-seerumi!

Päivän antioksidantti: ANTOSYAANI
Tänään tapaamme jälleen värillisen antioksidantin; sinisen, punaisen ja violetin sävyjä kasveihin tuovan antosyaanin. Eilen esitellyn EGCG:n tavoin antosyaani kuuluu fenolisiin yhdisteisiin, tarkemmin sanottuna flavonoidien alaluokkaan.
Antosyaania on runsaasti sinivioleteissa marjoissa ja hedelmissä kuten mustikassa, luumussa, tummissa viinirypäleissä, mustaherukassa ja aroniassa.
Antosyaania käytetään kosmetiikassa harvoin eristettynä, vaan se tulee ihonhoitotuotteeseen kasvi- tai marjauutteen mukana. Yleisimpiin lähteisiin kuuluvat mustikan ja mustaherukan uutteet. Huom! Ei siemenöljy, vaan koko marjasta valmistettu uute, sillä antosyaani sijaitsee marjojen kuoressa. Incistä tunnistat nämä esimerkiksi nimillä Vaccinium Myrtillus Fruit Extract (mustikka) tai Ribes Nigrum Fruit Extract (mustaherukka).

Antosyaanin ihohyötyjä:
1. Voimakas antioksidanttisuoja. Antosyaanit neutraloivat tehokkaasti vapaita radikaaleja ja suojaavat ihoa mm. saasteiden, UV-säteilyn sekä stressin aikaansaamilta vapailta radikaaleilta. (Kyllä, myös kehon sisäinen stressi aiheuttaa vapaita radikaaleja.)
2. Hillitsee tulehdusta ja punoitusta. Antosyaani rauhoittaa ärtynyttä ja reaktiivista ihoa.
3. Vahvistaa mikroverenkiertoa. Yksi antosyaanien erityispiirteistä on niiden kyky vahvistaa verisuonten seinämiä ja parantaa mikroverenkiertoa. Tästä voi olla apua tummien silmänalusten hoidossa sekä couperosa-ihon punoituksen rauhoittamisessa.
4. Suojaa kollageenia ja elastiinia. Antosyaanit estävät kollageenia ja elastiinia hajottavien MMP-entsyymien toimintaa.
5. Lievittää UV-vaurioita. Antosyaanit vähentävät UV-säteilyn aiheuttamaa oksidatiivista stressiä sekä tukevat DNA:n korjausprosesseja.

Tuotteen on lahjoittanut: Transmeri
Arvonta sulkeutunut. Luukun voittaja on nimimerkki AnnA.
Mossan Youth Defence -päivävoide kosteuttaa, rauhoittaa ja suojaa ihoa antioksidanttisesti. Ihanan tuoksuinen voide sisältää laventelivettä, mustikkauutetta, jojobaöljyä, E-vitamiinia ja humektantteja kuten glyserolia, natrium-PCA:ta ja hyaluronihappoa.
Voide sopii ihanteellisesti normaalista sekaiholle, myös rasvoittuvalle iholle.

Päivän antioksidantti: EGCG eli EPIGALLOKATEKIINIGALLAATTI
Tämän päivän antioksidantti onkin varsinainen sanahirviö, eikä ihmekään, että se on lyhennetty muotoon EGCG! 😅
EGCG kuuluu flavonoidien antioksidanttiryhmään ja on tarkemmin sanottuna katekiini. EGCG:tä saadaan teestä, ennen kaikkea vihreästä teestä. EGCG on vihreän teen tehokkain ja tutkituin aktiiviaine. Vihreän teen antioksidanttiset hyödyt tulevat juuri katekiineista, joista EGCG on aktiivisin ja muodostaa 50-60%
Kosmetiikassa EGCG:tä käytetään sekä eristettynä että osana tee-uutetta. Kun halutaan mahdollisimman tehokas EGCG:n vaikutus, käytetään vakioitua EGCG:tä.
Tunnistat EGCG:n incistä nimellä Epigallocatechin Gallate tai Epigallocatechin Gallatyl Glucoside. Glukosidi-muoto on stabiilimpi versio kuin puhdas EGCG. Vihreän teen tunnistat incistä nimellä Camellia Sinensis Leaf Extract.

EGCG:n ihohyötyjä (joita on paljon..!):
1. Äärimmäisen vahva antioksidantti. Tässä meillä on jälleen antioksidantti, joka on monin verroin tehokkaampi neutraloimaan vapaita radikaaleja kuin ”kultainen standardi” C- tai E-vitamiini. EGCG suojaa soluja oksidatiiviselta stressiltä ja hidastaa ihon ennenaikaista ikääntymistä.
2. Rauhoittaa tulehdusta. EGCG rauhoittaa tehokkaasti ärtynyttä ihoa. Se sopii erinomaisesti tuotteisiin, jotka on suunnattu esimerkiksi ruusufinnin (rosacea) tai herkän ihon hoitoon.
3. Hillitsee aknea. (Tämä oli jopa mullekin uusi tieto, jonka opin tehdessäni taustatyötä joulukalenterin luukkuihin...!) EGCG:n on osoitettu vähentävän talintuotantoa ja tulehduksellisia finnejä ja hillitsevän C. Acnes -bakteerin kasvua. Se on yksi harvoista antioksidanteista, joka auttaa suoraan epäpuhtauksien hallinnassa.
4. Suojaa ihoa UV-säteilyn haittavaikutuksilta. EGCG auttaa ehkäisemään UV-säteilyn aiheuttamia vaurioita ja hillitsemään eryteemaa eli auringon aiheuttamaa punoitusta. EGCG tukee myös ihon omaa DNA:n korjausmekanismia UV-altistuksen jälkeen.
5. Vähentää pigmenttimuutoksia. EGCG hillitsee ihossa tyrosinaasi-entsyymin toimintaa, mikä vähentää liikapigmentin muodostumista.
6. Suojaa elastiinia ja kollageenia hajoamiselta. EGCG estää kollageenia ja elastiinia hajottavan MMP-entsyymien aktiivisuutta.

Tuotteen on lahjoittanut: Transmeri
Arvonta sulkeutunut. Luukun voittaja on nimimerkki Johanna
Ahh, yksi lemppariseerumeistani! Tässä maitomaisessa seerumissa on peräti 57% aktiivianeita! 💪 Green Tea Polyphenols -seerumi on kehitetty ehkäisemään sekä vaalentamaan pigmenttiläiskiä, mutta sillä on myös rauhoittava ja kosteuttava vaikutus, ja se tuo iholle erittäin tehokkaan antioksidantti-suojan. Upeassa koostumuksessa on EGCG:n lisäksi mm. aloe veraa, merinarsissia, Lactobacillus-uutetta ja ruskolevää.
Olen sanonut Novexpertin Polyphenols-seerumista, että se on mielestäni paras ”yleis-anti-age”-seerumi, sillä se suojaa ihoa niin tehokkaasti ympäristörasitteilta ja sopii ihan kaikille ihotyypeille. Tämän tyyppinen voimakas antioksidanttiseerumi on myös loistovalinta ensimmäiseksi anti-age-seerumiksi. Tai siis PRO-age, yritän pysyä nyt tässä myönteisemmässä ilmaisussa! ☺️ Jos lisätieto Polyphenols-seerumista kiinnostaa, lue täältä mun esittely koko hienosta Green Tea Polyphenols -tuotelinjasta.

Päivän antioksidantti: AVENANTRAMIDI
Tämän päiväisessä kalenteriluukussa tapaamme kauran sisältämän antioksidantin, avenantramidin. Avenantramidi kuuluu polyfenolisiin yhdisteisiin ja tunnetaan erittäin vahvasta rauhoittavasta vaikutuksestaan. Kaurassa on monia hyödyllisiä yhdisteitä kuten lipidejä ja beetaglukaania, mutta juuri avenantramidi on se yhdiste, joka tekee kaurasta niin poikkeuksellisen tehokkaan aktiiviaineen hillitsemään ihon kutinaa ja ärsytystä. Avenantramidia voi siis pitää etenkin atoopikkojen supersankarina!
Avenantramideja on ainoastaan kaurassa. Ne ovat kauran omia puolustusaineita, joita se alkaa tuottaa erityisesti silloin, kun se joutuu stressiin, kuten altistuessaan sienitaudeille tai ympäristön rasitukselle. Olette ehkä kalenterin luukuista jo huomanneetkin, että antioksidantit ovat kasvien keino suojautua ympäristörasitukselta – ja siinä tarkoituksessa niitä lisätään myös ihonhoitotuotteisiin.

Avenantramidin ihohyötyjä:
1. Vahva kutinan lievittäminen. Tämä on avenantramidien tunnetuin ominaisuus. Ne estävät histamiinin vapautumista ja hillitsevät kutinaa erittäin tehokkaasti.
2. Anti-inflammatorinen vaikutus. Avenantramidit estävät tulehdusta välittävien sytokiinien toimintaa iholla rauhoittaen punoitusta ja ihoärsytystä jo pienillä pitoisuuksilla.
3. Antioksidanttinen suoja. Kuten muutkin polyfenolit, avenantramidit neutraloivat vapaita radikaaleja. Ne suojaavat ihoa mm. UV-säteilyn aiheuttamalta oksidatiiviselta stressiltä ja ehkäisevät aurinkovaurioiden syntymistä.
Avenantramidi tulee kosmetiikkaan aina osana kaura-ainesosia, sitä ei käytetä eristettynä. Tunnistat avenantramidin incistä kaura-aineiden nimillä kuten Avena Sativa Kernel Flour (kolloidinen kaura, käytännössä kaurajauhe), Avena Sativa Kernel Extract (kauranjyväuute) ja Avena Sativa Kernel Oil (kauraöljy). Jyväuutteet ja -jauhe sisältävät enemmän avenantramideja kuin öljy.

Tuotteet on lahjoittanut: Fiini Naturally
Arvonta sulkeutunut. Luukun voittaja on nimimerkki Pia.
Tänään meitä hemmotellaan kahden ultrarauhoittavan & kosteuttavan tuotteen setillä! 😍 Fiinin upeat kaura-pohjaiset tuotteet ovat loistovalinta kosteuttamaan ja rauhoittamaan kuivaa, herkkää ja atooppista ihoa.
Kaura & Kamomilla -hoitoveden minimalistinen koostumus sisältää rauhoittavan kamomillavesipohjan, johon on lisätty kauranjyväuutetta, glyserolia ja hyaluronihappoa. Tämä paksu neste on niin mahtava kosteuttaja että oksat pois – tässä ei ole pelkästään tehokas pitoisuus kauraa vaan myös korkeat pitoisuudet humektantteja.
Kaura & Probiootti -seerumi on hoitonesteen seerumi-serkku. Myös tässä on kamomillavesipohja ja runsaasti kauraa, glyserolia ja hyaluronihappoa, lisänä kosteuttavaa ja antibakteerista ksylitolia sekä fermentoitua Lactobacillusta, joka on probioottinen, ihoa rauhoittava ja mikrobiomia tukeva aine.

Päivän antioksidantti: FUKOKSANTIINI
Tänään palaamme levien mielenkiintoisten yhdisteiden pariin. Joulukalenterissa on jo esitelty florotanniini ja astaksantiini, tänään on vuorossa kolmas tehokas levien tuottama antioksidantti: fukoksantiini.
Fukoksantiinia esiintyy ruskolevissä ja se kuuluu antioksidantti-luokitukseltaan karotenoideihin. Se tuo ruskolevään ruskean tai oranssinruskean sävyn. Kuten muutkin levien pigmentti-antioksidantit, myös fukoksantiinin tehtävä on suojata levää auringon ultraviolettisäteilyltä. Sillä on kuitenkin kaksoisrooli: se sekä suojaa levää valolta, mutta myös auttaa levän klorofylliä keräämään auringonvaloa fotosynteesissä. Ei mennä tähän rooliin sen syvemmin tässä joulukalenteri-luukussa (ehkä kirjoitan joskus kokonaan levien yhdisteille omistetun postauksen 😍), mutta sanonpahan vain, että levien kemialliset ominaisuudet ovat loputtoman kiehtovia.

Fukoksantiinin ihohyötyjä:
1. Vahva antioksidantti. Auttaa suojaamaan ihoa hapettumisstressiltä ja ennenaikaiselta ikääntymiseltä.
2. Rauhoittaa tulehdusta. Fukoksantiini estää tehokkaasti tulehdusvälittäjäaineiden, kuten sytokiinien, toimintaa. Tämä tekee siitä hyödyllisen raaka-aineen ärtyneen, punoittavan tai akneen taipuvaisen ihon rauhoittamisessa.
3. Kirkastaa ihoa ja hillitsee pigmenttimuutoksia. Fukoksantiinin on todettu hillitsevän tyrosinaasi-entsyymiä, joka on avainasemassa melaniinin (väripigmentin) muodostumisessa.
4. Lievittää UV-säteilyn haittavaikutuksia. Fukoksantiini on pätevä neutraloimaan UV-säteilyn synnyttämiä vapaita radikaaleja. Se auttaa ehkäisemään valovanhenemista suojaamalla soluja DNA-vaurioilta ja lipidien hapettumiselta.

Tuotteen on lahjoittanut: Twistbe
Arvonta sulkeutunut. Luukun voittaja on Rauni Nalli.
Viron Saarenmaalta kotoisin oleva By Mukk -brändi on leväkosmetiikan huippusarja, ja (lähes) kaikissa sarjan tuotteissa hyödynnetään runsaasti merilevää. Monipuolisimmat levätehot löytyvät sarjan kasvovoiteista, joista valitsin joulukalenteriin täyteläisen Rich Day Cream’in. Se sopii kuivalle iholle ja talven ihonhoitoon muillekin ihotyypeille.
Rich Day Cream sisältää neljää eri levää, joukossa myös fukoksantiini-pitoinen ruskolevä Undaria Pinnatifida (tunnetaan paremmin wakame’na).
Rich Cream -voiteen sisältämät aprikoosinkiviöljy ja jojobaöljy kosteuttavat ihoa ja parantavat ihon elastisuutta, ruusunmarjaöljy uudistaa ja silottaa, sheavoi pehmentää ja suojaa. Aivan fantastisen laadukas voide! Vinkkinä: seka- ja rasvoittuvalle iholle sopii paremmin By Mukk’in Light Day Cream.

Päivän antioksidantti: PYCNOGENOL
Pycnogenol on erityinen antioksidantti; se on nimittäin patentoitu sellainen, ja valmistettu ranskalaisen merimännyn (Pinus Pinaster) kuoresta. Pycnogenol koostuu pääosin proantosyanidiineista, joihin tutustuimme luukussa 13, ja mukana yhdisteessä on myös flavonoideja sekä fenolihappoja kuten ferulahappoa ja kanelihappoa. Tämä yhdistelmä sekä vakioitu koostumus erottaa Pycnogenolin muista männynkuoriuutteista.
Pycnogenol on yksi tieteellisesti tutkituimmista luonnollisista uutteista maailmassa. Pycnogenolin hyödyt perustuvat sen erittäin voimakkaaseen antioksidanttiseen ja tulehdusta hillitsevään vaikutukseen.

Pycnogenolin ihohyötyjä:
1. Monipuolinen ja voimakas antioksidantti. Pycnogenol neutraloi tehokkaasti monenlaisia vapaita radikaaleja, suojaten ihoa UV-säteilyn, saasteiden ja muiden ympäristötekijöiden aiheuttamalta oksidatiiviselta stressiltä.
2. Suojaa kollageenia ja elastiinia. Pycnogenolin sisältämät proantosyanidiinit sitoutuvat kollageeniin ja elastiiniin, suojaten niitä entsymaattiselta hajoamiselta. Tämä auttaa ylläpitämään ihon kimmoisuutta ja vähentämään ryppyjä.
3. Hillitsee tulehdusta. Pycnogenolilla on vahva anti-inflammatorinen vaikutus, joka rauhoittaa ihoa ja auttaa vähentämään punoitusta ja tulehdustiloja, kuten UV-altistuksen jälkeistä ihoärtymystä.
4. Parantaa ihon kosteutta ja kimmoisuutta. Tutkimukset viittaavat siihen, että Pycnogenol voi tukea ihon hyaluronihapon tuotantoa, mikä parantaa ihon kosteuspitoisuutta.

Tuotteen on lahjoittanut: Ihola Oy
Arvonta sulkeutunut. Luukun voittaja on nimimerkki Taru.
Vesipohjainen ja raikas Pycnogenol-seerumi kosteuttaa ihoa ja tuo voimakasta antioksidanttista suojaa. Valmistajan mukaan Pycnogenolin antioksidanttinen teho olisi jopa 350 kertaa vahvempi kuin C-vitamiinilla ja 170 kertaa vahvempi kuin E-vitamiinilla.
Pycnogenol-seerumi sopii loistavasti nuoren aikuisen ensimmäiseksi pro-age-seerumiksi hidastamaan ympäristöstressin aikaansaamia ikääntymisen merkkejä. C-vitamiini-seerumin tavoin se sopii mainiosti myös aurinkovoiteen alle vahvistamaan aurinkovoiteen suojatehoa UV-säteilyn haittavaikutuksia vastaan.
Hajusteeton ja minimalistinen seerumi sopii oivallisesti myös herkälle iholle.

Päivän antioksidantti: E-vitamiini
E-vitamiini on yksi hyödyllisimmistä antioksidanteista kosmetiikassa, koska sillä on kaksoisrooli: se suojaa sekä tuotetta että ihoa hapettumiselta.
Tästä syystä E-vitamiini onkin lähes standardilisä öljyjä tai rasvoja sisältävissä kosmetiikkatuotteissa. E-vitamiini suojaa ihonhoitotuotteen sisältämiä öljyjä härskiintymiseltä, mikä pidentää tuotteen käyttöikää. Voit esimerkiksi bongata E-vitamiinin hyvin monista kasvoöljyistä sekä kasvovoiteista.
Iholla E-vitamiini suojaa solukalvoja. Se on tehokas parivaljakko bestiksensä C-vitamiinin kanssa; E neutraloi rasvaliukoisia vapaita radikaaleja, C vesiliukoisia. Kolmas jäsen tässä tiiviissä ystäväporukassa on ferulahappo, kerroin tästä synergisesti toimivasta kolmikosta luukussa 4. Yhdessä E-vitamiini, C-vitamiini ja ferulahappo muodostavat kosmeettisen antioksidanttisuojan ”kultaisen standardin”.

E-vitamiinin ihohyötyjä:
1.Tehokas antioksidanttisuoja. E-vitamiini on rasvaliukoinen antioksidantti, mikä tarkoittaa, että se kykenee suojaamaan ihon solukalvoissa olevia lipidejä vaurioilta. Se neutraloi tehokkaasti vapaita radikaaleja, jotka syntyvät UV-säteilyn, ilmansaasteiden ja muiden ympäristötekijöiden vaikutuksesta.
2. Vahvistaa ihon suojakerrosta ja kosteuttaa. E-vitamiini suojaa ihon suojakerroksen lipidejä kuten keramideja ja rasvahappoja, mikä auttaa vähentämään transepidermaalista vedenhaihtumista (TEWL). Tämä parantaa ihon kosteustasapainoa.
3. Lievittää UV-vaurioita. E-vitamiini lievittää ultravioletti-säteilyn aikaansaamia soluvaurioita. Se tekee sen hillitsemällä UV-säteilyn indusoimaa tulehdusta ja vähentämällä eryteemaa (palamisesta johtuvaa punoitusta).
4. Voi edistää arpien ja pienten haavojen paranemista. Joidenkin tutkimusten mukaan E-vitamiini voi edistää kudosvaurioiden kuten pienten naarmujen ja arpien paranemista. E-vitamiini ei korjaa ihoa stimuloimalla kollageenia, mutta tukee ihon paranemisprosessia antioksidanttisella, tulehdusta hillitsevällä sekä ihon lipidikerrosta vahvistavalla vaikutuksellaan.

E-vitamiinia esiintyy luonnossa kahdessa muodossa: tokoferoleina ja tokotrienoleina. Näitäkin on kumpaakin vielä neljää eri muotoa (alfa, beta, gamma ja delta), joista alfa-muoto on ihossa biologisesti aktiivisin.
Kosmetiikassa E-vitamiinia käytetään sekä eristettynä että osana kasviöljyjä. Monet kasviöljyt kuten oliivi, jojoba, auringonkukka ja rypsi sisältävät runsaasti E-vitamiinia.
Eristettynä E-vitamiinin bongaa incistä nimellä Tocopherol (voi olla luonnollinen tai synteettinen) tai Tocopheryl Acetate (synteettinen).
Tocopherol on näistä kahdesta biologisesti aktiivisempi, kun taas Tocopheryl Acetaten etuna voi pitää sen parempaa stabiiliutta.

Tuotteen on lahjoittanut: House Of Organic
Arvonta sulkeutunut. Luukun voittaja on nimimerkki Teekoo.
Bioearthin E-vitamiini-boosteri sisältää 2% E-vitamiinia MCT- ja arganöljy-pohjassa. Voit boosterin avulla lisätä mihin tahansa ihonhoitotuotteeseen E-vitamiinia, tai halutessaan tuotetta voi käyttää iholla myös sellaisenaan seerumin tavoin.
Mukana arvonnassa on myös Bioearth-linjan neutraali Base Cream -kasvovoide, joka on tarkoitettu boostereiden pohjaksi. Asiakas voi ostaa Bioearthin Base Cream -voiteen ja tuunata siihen Elementa-boostereilla haluamansalainen aktiiviaine-cocktail. Elementa-linjaan kuuluu useita eri boostereita.

Päivän antioksidantti: LYKOPEENI
Tämän päivän antioksidanttimme lykopeeni on UV-peräisen stressin hallinnan todellinen supersankari! Laita tämä antioksidantti mieleen, kun haet hyvää antioksidanttia tukemaan ihon suojaa aurinkoaltistuksessa.
Lykopeeni on karotenoideihin kuuluva antioksidantti, joka antaa tomaateille ja muille punaisille hedelmille ja vihanneksille niiden värin. Tunnetuin ja runsain lykopeenin lähde on tomaatti. Myös punainen vesimeloni sekä guava sisältävät paljon lykopeenia.

Lykopeenin ihohyötyjä:
1. Vahva antioksidanttisuoja. Rasvaliukoisena antioksidanttina lykopeeni pystyy asettumaan solukalvoille, ja se suojelee solukalvoja sekä DNA:ta oksidatiiviselta stressiltä.
(Antioksidantteja on sekä vesi- että rasvaliukoisia, samoin vapaita radikaaleja. Ihonhoidossa tulee ihanteellisesti käyttää sekä vesi- että rasvaliukoisia antioksidantteja, jotta voidaan torjua pahis-radikaaleja sekä ROSeja mahdollisimman laajalla spektrillä.)
2. Ehkäisee ihon valovaurioita. Beetakaroteenin tavoin lykopeeni toimii ”sisäisenä aurinkosuojana” ja auttaa vähentämään UV-säteilyn aiheuttamia vaurioita kuten eryteemaa (punoitusta), tulehdusta ja ihon ennenaikaista ikääntymistä.
3. Hillitsee tulehdusta. Lykopeenilla on anti-inflammatorisia ominaisuuksia ja se on hyvä aine tukemaan herkkää ja reaktiivista ihoa. Tutkimukset osoittavat lykopeenin rauhoittavan erityisesti UV-säteilyn sekä muun ympäristöstressin aiheuttamaa tulehdusta.
4. Suojaa kollageenia. Lykopeeni vähentää kollageenia ja elastiinia hajottavien MMP-entsyymien toimintaa (ja juuri UV-säteily stimuloi MMP-entsyymejä).
Lykopeeni on rasvaliukoinen yhdiste ja vaikuttaa iholla parhaiten öljypohjaisessa tuotteessa, mieluusti kasvoöljyssä. Tunnistat lykopeenin inci-listasta nimellä Lycopene tai osana kasviuutteita kuten Solanum Lycopersicum Extract (tomaatti), Citrullus Lanatus Fruit Extract (vesimeloni) tai Psidium Guajava Fruit Extract (guava).

Tuotteen on lahjoittanut: Transmeri
Arvonta sulkeutunut. Luukun voittaja on nimimerkki Heidi.
Mossan legendaarinen Vitamin Cocktail -öljy pursuaa antioksidanttisia uutteita niin paljon, että ”näköä haittaa". 😄 Aivan kärjessä on tomaattiuutetta, kannoillaan ruusunmarjaa, tyrniä, vadelmaa, avokadoa, oliivia ja kauraa, kaikki näistä pursuavat ihoa suojaavia ja vahvistavia ravinteita. Öljyn pohjan muodostaa kaikille ihotyypeille sopiva jojobaöljy.
Jos et ole vielä kokeillut tätä kosmetiikka-scenen suosituimpiin kuuluvaa kasvoöljyä, nyt siihen tarjoutuu tilaisuus.

Päivän antioksidantti: PROANTOSYANIDIINI
Proantosyanidiinit ovat kasveissa esiintyviä flavonoidi-pohjaisia yhdisteitä, joita esiintyy runsaasti esimerkiksi rypäleensiemenissä, kuusen ja männyn kuoressa sekä marjoissa kuten mustikassa.
Proantosyanidiinien ihohyötyjä:
1. Voimakas antioksidanttisuoja. Proantosyanidiinit torjuvat vapaita radikaaleja ja niitä pidetään jopa vahvempina antioksidantteina kuin C- ja E-vitamiinia (nämä kaksi ovat muuten kosmetiikan antioksidanttien ”kultainen standardi”, ja siksi muiden antioksidanttien tehoa verrataan usein juuri näihin.
2. Suojaa kollageenia ja elastiinia. Proantosyanidiinit voivat vahvistaa kollageenin rakennetta ja estää sen hajoamista. Tämä auttaa säilyttämään ihon kimmoisuutta ja vähentämään ryppyjä.
3 .Ehkäisee pigmenttimuutoksia. Proantosyanidiinit hillitsevät tyrosinaasi-entsyymin aktiivisuutta, mikä vähentää hyperpigmentaatiota.
4. Rauhoittaa tulehdusta. Proantosyanidiinit voivat hillitä ihon tulehdusreittejä, mikä auttaa rauhoittamaan ihoärtymystä ja vähentämään punoitusta. Proantosyanidiinien sanotaan myös voivan vahvistaa verisuonia, mikä vähentää hauraiden pintaverisuonten aikaansaamaa ihon punoitusta, kuten couperosaa.

Proantosyanidiinit ovat vesiliukoisia yhdisteitä ja sijaitsevat pääsääntöisesti kasvin kuoressa ja siemenissä. Jos tavoitellaan proantosyanidiinien hyötyjä esimerkiksi viinirypäleestä, käytetään viinirypäleen siemenuutetta, ei siemenöljyä.
Siemenuutteen tunnistaa incistä nimellä Vitis Vinifera Seed Extract, kun taas öljy on Vitis Vinifera Seed Oil. Siemenuute valmistetaan liuottamalla siemenistä bioaktiiviset yhdisteet, tyypillisesti vedellä tai etanolilla.

Tuotteen on lahjoittanut: Twistbe
Arvonta sulkeutunut. Luukun voittaja on nimimerkki Karla.
Uusiseelantilainen luonnonkosmetiikkabrändi Antipodes hyödyntää antioksidanttirikasta rypäleensiemenuutetta nimeltä Vinanza® useissa tuotteissaan, ihana Vanilla Pod -päivävoide on yksi niistä. Vinanza®-uute valmistetaan Marlboroughin alueen Sauvignon Blanc -rypäleistä, ja uusiseelantilaisen tutkimuksen mukaan se sisältää tuplasti saman verran polyfenolisia antioksidantteja, kuin muut viinirypäleuutteet.
Upean Vanilla Pod -voiteen täyteläisessä koostumuksessa ihoa hoitavat rypäleuutteen ohella skvalaani, sheavoi, ruusunmarja- ja makadamiansiemenöljy, hunaja ja avokadoöljy. Voide sopii ihanteellisesti kuivalle iholle ja hoitamaan ikääntymismuutoksia.

Päivän antioksidantti: CANNABIDIOL eli CBD
Tiesittekös, että tämäkin aine on antioksidantti? 🙂 Ja hyvinkin tehokas sellainen – joidenkin tutkimusten mukaan CBD olisi jopa tehokkaampi vapaiden radikaalien sieppaaja kuin C- ja E-vitamiini.
Cannabidiol eli suomeksi kannabidioli on yksi hamppukasvin yhdisteitä, mutta sillä ei ole päihdyttävää tai psykoaktiivista vaikutusta. Älä sekoita cannabidiolia THC:hen!
Cannabidiol on voimakkaasti anti-inflammatorinen eli tulehdusta rauhoittava – sekä myös kipua lievittävä - aine, ja tätä ominaisuutta hyödynnetään muissa maissa myös sisäiseen kivun ja tulehduksen lievitykseen. Suomessa CBD on sallittu kosmetiikassa, mutta ei (vielä) elintarvikkeissa tai ravintolisissä.

CBD:n ihohyötyjä:
1. Vahva antioksidantti: neutraloi vapaita radikaaleja tehokkaasti, suojaten soluja hapettumisstressiltä. Tämä on suora antioksidanttinen vaikutus, mutta CBD:llä on myös epäsuora antioksidanttinen hyöty: se parantaa kehon omien, endogeenisten antioksidanttien kuten glutationin ja superoksididismutaasin tuotantoa.
2. Rauhoittaa ihoa: CBD hillitsee elimistössä tulehdusreittejä, mikä vähentää tulehdusreaktioiden voimakkuutta. Käytännössä tämä tarkoittaa, että oireet kuten punoitus, turvotus, ärtymys ja aknen tai atopian kaltaisten tulehduksellisten ihotilojen oireet lievittyvät.
3. Hillitsee talintuotantoa. Tutkimukset ovat osoittaneet, että CBD kykenee vähentämään rasvojen synteesiä talirauhasissa.

Tuotteen on lahjoittanut: Blank&
Arvonta sulkeutunut. Luukun voittaja on nimimerkki Saara.
Vuoden parhaisiin tuotelöytöihin kuuluva kasvovesi Veya Glass Glow Mist kosteuttaa aivan tautisen tehokkaasti, samalla rauhoittaen ihoa ja luoden iholle kauniin hehkun.
Lähes kaikki meistä ihoaan hoitavista ihmisistä käyttävät kasvovettä (mutta läheskään kaikki eivät käytä kasvoöljyä), siksi pyysin Blank&’ilta palkinnoksi tähän luukkuun juuri Veyan. Tämä on NIIN ihana! 😍
Veya sisältää korkean pitoisuuden humektantteja kuten betaiinia, glyserolia ja dekstriiniä, CBD:n huolehtiessa ihon rauhoittamisesta ja antioksidanttisesta suojasta. Hurmaavan tuoksun luovat kardemumma, laventeli ja rosmariini.

Päivän antioksidantti: ELLAGIINIHAPPO
Ellagiinihappo on fenolisiin yhdisteisiin kuuluva antioksidantti, jota esiintyy erityisen paljon marjoissa kuten vadelmissa, mansikoissa ja karhunvatukoissa. Myös granaattiomena, saksanpähkinä ja pekaanipähkinä ovat hyviä ellagiinihapon lähteitä.
Ellagiinihapon hyödyt iholle voidaan jakaa kolmeen pääluokkaan: suojaavaan, rauhoittavaan ja kirkastavaan vaikutukseen.
1. Antioksidanttinen suoja: ellagiinihappo neutraloi vapaita radikaaleja ja suojaa ihosoluja oksidatiiviselta stressiltä.
2. Rauhoittaa tulehdusta: ellagiinihappo rauhoittaa tulehdusreaktioita iholla.
3. Kirkastaa ihoa ja lievittää pigmenttiläiskiä: ellagiinihapon on osoitettu hillitsevän tyrosinaasi-entsyymiä sekä vähentävän melanosomien muodostumista, mikä lievittää ihon liikapigmentaatiota.
4. Suojaa kollageenia: ellagiinihapon on myös joissain tutkimuksissa todettu vähentävän kollageenia hajottavien MMP-entsyymien aktiivisuutta.

Ellagiiniahappo tulee kosmetiikkatuotteisiin useimmiten vadelma- tai granaattiomenauutteen mukana, mutta sitä käytetään myös eristettynä molekyylinä, jolloin tunnistat sen incistä nimellä Ellagic Acid.

Tuotteet on lahjoittanut: Purodoré
Arvonta sulkeutunut. Luukun voittaja on Jaana Kiviniemi.
Tänään meillä on kaksikin ihanaa kotimaista tuotetta arvottavana 😍: kosteuttava, ruusuvesipohjainen Balancing Day & Night Cream sekä auringolta suojaava SPF-päivävoide Active Day Cream SPF 25. Kumpikin sisältää vadelmaa.
Balancing-voiteen ihanasti kosteuttava ja rauhoittava koostumus sisältää ruusuvettä, jojoba-, ruusunmarja- ja arganöljyä, sheavoita sekä vadelman, kauran ja kamomillan uutteita. Balancing Day & Night Cream sopii erityisen hyvin herkälle, normaalille ja kuivalle iholle.
Active Day Cream SPF 25 -voide sisältää antioksidanttisten öljyjen ja uutteiden todellisen superbuffetin: vadelmansiemenöljyä, avokadoöljyä, sheavoita, aprikoosinkivi- ja hampunsiemenöljyä, porkkanöljyä, agave-, annatto- ja camu camu -hedelmän uutetta sekä mustaherukan siemenöljyä. Suojakertoimella 25 varustettu päivävoide soveltuu mainiosti vaikkapa kevätaurinkoon suojaamaan ihoa, kun UV-indeksi ei vielä ole kovin korkea. Toki SPF-päivävoidetta voi käyttää vuoden ympäri.

Päivän antioksidantti: C-VITAMIINI (rasvaliukoinen muoto)
Saatat kysyä; hetkinen, eikös C-vitamiini jo ollut yhdessä luukussa? Aivan oikein, se oli – mutta tänään vuorossa on rasvaliukoinen C-vitamiini-johdannainen. C-vitamiini on niin tärkeä antioksidantti – ja C-vitamiini-muotoja niin monia – että se ansaitsee useammankin luukun. 😌 Samalla tutustutte eri tyyppisiin C-vitamiineihin.
Puhdas C-vitamiini eli askorniinihappo on vesiliukoinen, kuten on myös valtaosa johdannaisista, mutta joukossa on muutama rasvaliukoinenkin laatu. Tehokkain näistä on Ascorbyl Tetraisopalmitate (tunnetaan myös nimellä Tetrahexyl Ascorbate, kemiallisesti sama molekyyli). Ascorbyl Tetraisopalmitate on muodostettu liittämällä -askorbiinihappoon neljä pitkäketjuista rasvahappoa; isopalmitiinihappoa.
🧪 🧫 Rasvaliukoisen aktiiviaineen etuna vesiliukoiseen nähden on paremman imeytyvyyden potentiaali: epidermiksen suojakerros koostuu lipideistä, ja ne päästävät paremmin läpi toisia lipidejä eli rasvoja. Verrattuna vesiliukoisiin C-vitamiiniyhdisteisiin, ”tetra”-C-vitamiini imeytyykin ihoon helpommin ja syvemmälle. Jos sen tehoa vertaa aiemmassa C-vitamiini-luukussa esittelemääni vesiliukoiseen askorbyyliglukosidiin, tetra-C-muotoa pidetään hieman tehokkaampana etenkin kollageenin aktivoinnissa. Se sopii myös paremmin kuivaihoisille, sillä se formuloidaan tyypillisesti öljyvoittoisiin voide/seerumi-pohjiin.

Tetra-C-vitamiinin ihohyödyt:
Tarjoaa kaikki samat hyödyt kuin puhdas C-vitamiini, eli:
1. Tehokas antioksidantti eli sieppaa vapaita radikaaleja
2. Kirkastaa ihoa ja hillitsee liikapigmentaatiota
3. Aktivoi ihossa kollageenin tuotantoa.
Vaikutukset vain saattavat olla hitaampia kuin puhtaalla C-vitamiinilla. Teho riippuu myös pitoisuudesta. Tetra-C ei ole yhtä ärsyttävä kuin puhdas C-vitamiini, ja sopii alhaisemmilla pitoisuuksilla (max 5%) myös herkkäihoiselle ja C-vitamiinin vasta-alkajalle.

Tuotteen on lahjoittanut: Korres
Arvonta sulkeutunut. Luukun voittaja on nimimerkki Heli.
Huikean hieno kaksifaasinen seerumi sisältää 15% Tetra-C-vitamiinia, seuranaan ruusunmarjaöljyä, skvalaania, ruskolevää, merinarsissia, kuusamaa, ruusuöljyä, moringaöljyä, pantenolia ja inkivääriuutetta. Tässä meillä on upea cocktail ihoa kirkastavia, uudistavia, kosteuttavia, suojaavia ja elvyttäviä aktiiviaineita. Kaiken lisäksi yksi ja sama tuote tuo iholle tehokkaasti sekä vesi- että öljykosteutta! Korresin Spotless-seerumi on ainesosiltaan ja kokonaisuudeltaan yksi parhaita tuntemiani seerumeita. 💎
Tuote sisältää sekä vesi- että öljyfaasin, joten muistathan ravistaa pulloa ennen käyttöä, jotta faasit yhdistyvät.

Päivän antioksidantti: KURKUMIINI
Kurkumiini on mausteena tunnetun kurkuman pääasiallinen aktiivinen yhdiste ja vastaa kurkuman keltaisesta väristä. (Monet antioksidantit ovat myös pigmenttejä..!) Antioksidanttiluokitukseltaan kurkumiini kuuluu polyfenoleihin.
Kurkumiini on saanut kosmetiikassa suosiota erityisesti tulehdusta hillitsevien ominaisuuksiensa vuoksi – sen ohella, että se on myös erittäin tehokas antioksidantti, ja kosmetiikassa rakastetaan antioksidanttisia hyötyjä..!
Kurkumiini on itse asiassa erään luokituksen tai näkemyksen mukaan yksi neljästä ”täydellisestä” eli mahdollisimman monipuoliset ja tehokkaat hyödyt omaavasta antioksidantista. Muut kolme on jo esitelty tässä kalenterissa: ferulahappo, astaksantiini ja resveratrol.
Kurkumiini tulee ihonhoitotuotteeseen kurkumauutteen mukana, bongaat sen incistä nimellä Curcuma Longa Root Extract.

Kurkumiinin ihohyötyjä:
1. Voimakkaaasti anti-inflammatorinen. Kurkumiini vähentää tulehdusta ja lievittää oireita esimerkiksi aknen, ruusufinnin ja atooppisen ekseeman kaltaisissa ihotiloissa. Se auttaa rauhoittamaan ärtynyttä ja punoittavaa ihoa.
2. Tehokas vapaiden radikaalien sieppaaja; suojaa ihosoluja oksidatiiviselta stressiltä.
3. Antimikrobinen. Torjuu bakteereita (mukaan lukien aknea aiheuttavaa C. acnes -bakteeria) sekä sieniä.

Tuotteen on lahjoittanut: Twistbe
Arvonta sulkeutunut. Luukun voittaja on nimimerkki Miina.
Tämä ihana balmi sisältää mielettömän buffetin vaikka sun mitä antioksidantteja 😍, kurkumiini on vain yksi niistä. Upea koostumus hellii ihoa mm. karpalon, tyrnin, vadelman ja unikon siemenöljyillä, mango- ja kokum-voilla, punalevän- mustikan ja papaijan uutteilla sekä joukolla ayurvedisiä yrttejä, joihin kurkumakin kuuluu. Olen intoillut tästä balmista pitkin syksyä, ja nyt se komeilee myös joulukalenterissani. ❤️🔥
Nymph Nectar -balmi sopii kaikille ihotyypeille, ihanteellisimmin normaalista kuivalle. Muistathan aina levittää balmin kasvovedellä kostutetulle iholle!
Osallistut arvontaan jättämällä tähän postaukseen vapaavalintaisen kommentin. Arvontaan voi osallistua 10.12. klo 9.00 saakka. Arvottuani voittajan poistan kommentit, jotta kommenttilaatikko tyhjenee seuraavan luukun arvontaa varten.

Päivän antioksidantti: Koentsyymi Q10 eli ubikinoni
Tänään tapaamme endogeenisen eli kehossamme luonnostaan esiintyvän antioksidantin. Koentsyymi Q10, joka tunnetaan myös ubikinonina, on elintärkeä solujen energiantuotannossa.
Ihonhoidossa Q10:n hyödyt liittyvät sen rooliin solujen suojaajana ja energiantuottajana. Juuri tuo energiantuotannollinen rooli erottaa ubikinonin monista muista antioksidanteista, harvalla antioksidantilla on tämä vaikutus.
Q10 on jo vuosikymmeniä ollut yksi kosmetiikkateollisuuden suosituimpia ja luotetuimpia antioksidantteja. Se on tieteellisesti hyvin tuettu ainesosa; Q10:n ihohyödyt ja vaikutukset on osoitettu lukuisissa kliinisissä testeissä.
Q10:n tunnistat incistä nimellä ubiquinone.
Koentsyymi Q10:n ihohyötyjä:
1. Tehokas vapaiden radikaalien sieppaaja, joka suojaa ihosoluja oksidatiiviselta stressiltä.
(Q10 on muuten C-vitamiinin tavoin E-vitamiinin erityisystävä! 😍 Se auttaa uudistamaan E-vitamiinia antamalla sille yhden elekroneistaan, kun E-vitamiini on luovuttanut omansa vapaalle radikaalille, ja näin E-vitamiini voi palautua takaisin aktiiviseksi antioksidantiksi.)
2. Tukee solujen energian tuotantoa; Q10 on välttämätön mitokondrioissa tapahtuvalle energian tuotannolle. Ikääntyessä Q10:n luonnollinen taso elimistössä laskee, mikä hidastaa solujen uusiutumiskykyä, ja kosmetiikan kautta iholle tuotu Q10 auttaa paikkaamaan tätä vajetta.
3. Suojaa kollageenia ja elastiinia. Kuten niin monet tehokkaat (ja Karkkipäivän joulukalenteriin päätyneet) antioksidantit, myös Q10 suojaa kollageenia ja elastiinia niitä hajottavilta MMP-entsyymeiltä. Kiitos solujen energiantuotantoa, uudistumista ja korjausprosesseja vahvistavan sekä kollageenia ja elastiinia suojaavan vaikutuksensa, Q10 ylläpitää ihon nuorekkuutta ja hidastaa tehokkaasti ikääntymismuutoksia.

Tuotteen on lahjoittanut: Transmeri
Arvonta sulkeutunut. Luukun voittaja on nimimerkki Lumia.
Jei, tänään luukussa on kaksi arvottavaa tuotetta! Lavera on ainoa tuntemani luonnonkosmetiikkasarja, jonka tuotteissa on ubikinonia. He ovat itse kehittäneet oman luonnollisen Q10-yhdisteen maissitärkkelyksestä fermentoinnin keinoin. Juuri ulkoasunsa uudistaneen Lavera Basis Sensitiv -linjan Q10-tuotteet ovat siis ainoa vaihtoehto, jos etsit luonnonmukaista Q10:iä. (Normikosmetiikan Q10 on synteettistä.)
Sekä Q10-päivävoide että -silmänympärysvoide ovat mukavan keskitäyteläisiä ja sopivat parhaiten normaalista kuivemmalle ja aikuiselle iholle.
Hoitavassa päivävoiteessa on Q10:n ohella mm. merikaalin öljyä, mangovoita, jojobaöljyä, aloe veraa, sheavoita ja oliiviöljyä. Silmänympärysvoiteessa on samoja ainesosia, mutta kevyemmällä rasvapitoisuudella.

Päivän antioksdantti: RESVERATROL
Ahh, tämän päivän luukussa on yksi suosikki-antioksidanttejani! 😍 Okei, niitä on monia… 😁
Resveratrol kuuluu fenolisiin yhdisteisiin. Sitä on merkittäviä määriä viinirypäleen kuoressa - ja sitä myöten myös punaviinissa. Resveratrol onkin yksi syistä, miksi punaviinillä katsotaan olevan terveysvaikutuksia – kohtuudella nautittuna tietysti. 🍷 Resveratrolia esiintyy myös joidenkin marjojen kuten mustikan, puolukan ja karhunvatukan, kuoressa.
Resveratrolia käytetään kosmetiikassa pääsääntöisesti kahden ominaisuuden vuoksi: se hillitsee liikapigmentaatiota sekä rauhoittaa ihoa. Saatat siis kohdata resveratrolia sekä rauhoittavissa ihonhoitotuotteissa (esimerkkinä vaikka Mossan puolukka-tuotelinja) että pigmenttiläiskiä ehkäisevissä tuotteissa.
Resveratrolin voi bongata incistä nimillä Resveratrol tai Hyxrodyresveratrol. Etenkin jälkimmäinen on erittäin teohokas pigmenntiläiskien vaalentaja. Resveratrolia voidaan tuoda ihonhoitotuotteisiin myös tiettyjen kasviuutteiden kuten puolukan ja mustikan mukana – mutta huom: ei viinirypäleen siemenöljyssä, sillä resveratrol sijaitsee rypäleen kuoressa, ei siemenissä.

Resveratrolin ihohyötyjä:
1. Vahva antioksidantti; neutraloi vapaita radikaaleja sekä reaktiivisia happilajeja (ROS)
(kun aiheena on ”antioksidantit”, en toisaalta tiedä, miksi toistan tätä ihohyötyä jokaisen antioksidantin kohdalla 😁 Kyllähän nämä kaikki neutraloivat vapaita radikaaleja. Muutamat vain ovat siinä vielä aivan poikkeuksellisen tehokkaita.)
2. Hillitsee tehokkassti liikapigmentin muodostumista; kirkastaa ihoa, vaalentaa jo olemassa olevia pigmenttiläiskiä ja ehkäisee uusien muodostumista.
3. Rauhoittaa tulehdusta. Erinomainen aine reaktiiviselle ja ärtyneelle iholle.
4. Hidastaa ikääntymismuutoksia. Resveratrolin on todettu aktivoivan SIRT1-geeniä, joka tunnetaan pitkäikäisyysgeeninä. Lisäksi resveratrol suojaa ihon kollageenia ja elastiinia hajoamiselta ja tukee DNA-korjausprosesseja.
5. Korjaa UV-vaurioita. (Seuraava tieto on vuonna 2009 ilmestyneestä ihotautilääkäri Matti Hannukselan kirjasta.) Hannukselan mukaan joissain tutkimuksissa on osoitettu, että resveratrol vähentää etenkin UVB-säteilyn vaurioita ihossa, jopa ihosyöpää. Joskus aikaa sitten on ollut myynnissä liialliseen auringonottoon ”katumusvoiteita”, joiden vaikuttavana aineena on ollut mm. resveratrolia..!

Tuotteen on lahjoittanut: House Of Organic
Arvonta sulkeutunut. Luukun voittaja on nimimerkki Taimi.
Monelle vakkariseuraajalleni varmasti tuttu tuote; tämä seerumi on mulle yksi viime vuosien parhaimpia ihonhoitotuotteita. Rakastan ihan kaikkea tässä tuotteessa: sen koostumusta, ihotuntumaa, tuoksua, kosteuttavuutta ja pigmenttiläiskiä hillitsevää tehoa. Niin ihana upea, ja ihanaa, että sain tämänkin mukaan antioksidantti-joulukalenteriini! 🤗
Emulsiomainen Resveratrol + Niacinamide -seerumi kosteuttaa ja pehmentää ihoa, tuo rutkasti antioksidanttista suojaa ja kirkastaa sekä ehkäisee pigmenttimuutoksia. Resveratrolin ihoa kirkastavaa vaikutusta tukee niasiiniamidi, joka sekin häivyttää hyperpigmentaatiota, mutta omaa myös muita ihon hyvää kuntoa ylläpitäviä ominaisuuksia.

💙🤍 Hyvää itsenäisyyspäivää 💙🤍
Päivän antioksidatti: KVERSETIINI
Kversetiini on tehokas kasviperäinen flavonoidi (polyfenolinen yhdiste), jota esiintyy mm. marjoissa, omenissa, kehäkukassa, teessä ja viinirypäleissä.
Kversetiinillä on monia hyötyjä ihonhoidossa, joista merkittävimpiin kuuluu tulehdusta hillitsevä vaikutus. Tästä syystä esimerkiksi kehäkukka, joka sisältää runsaasti kversetiiniä, on ihonhoidollisilta ominaisuuksiltaan niin rauhoittava ja suosittu ärtyneen ihon hoitotuotteissa.
Kversetiiniä voidaan käyttää kosmetiikassa eristettynä molekyylinä (incinimi Quercetin), mutta useimmin se tulee kasviuutteen mukana. Kehäkukka- ja marjauutteet (huom; ei marjansiemenöljy vaan marjan hedelmäuute) ovat tyypillisiä kversetiinin lähteitä ihonhoitotutteissa.

Kversetiinin ihohyötyjä:
1. Hillitsee tulehdusta ja lievttää ihon punoitusta (mm. vähentämällä histamiinin vapautumista)
2. Antioksidanttinen suoja; neutraloi tehokkaasti vapaita radikaaleja ja suojaa soluja hapettumisstressiltä.
3. Suojaa kollageenia. Kuten edellisessä luukussa tavattu florotanniini, kversetiini auttaa estämään kollageenia hajottavien entsyymien toimintaa ihossa.
4. Tehostaa UV-suojaa. Kuten ferulahappo, kversetiini toimii yhdessä muiden antioksidanttien ja aurinkosuojien kanssa tehostaen niiden suojaavaa vaikutusta valovaurioita vastaan.

Tuotteen on lahjoittanut: Frantsila
Arvonta sulkeutunut. Luukun voittajat ovat Magda, Enitta ja Katja Kallio.
Itsenäisyyspäivän kunniaksi tämän päivän luukussa kolme onnekasta voi voittaa itselleen Frantsilan upean Kehäkukka & C-vitamiini-seerumin. Kyllä: tässä seerumissa on myös C-vitamiinia, sitä samaa stabiilia ja hyvin siedettyä askorbiiliglukosidi-muotoa, jonka esittelin luukussa 4. Upea Calendula Glow -seerumi sisältää itse asiassa niin monia eri antioksidantteja, että se voisi olla mukana monessakin eri luukussa. 😍
Herkullisen sitrushedelmäisen tuoksuinen seerumi sisältää koivunmahlaa, C-vitamiinia, skvalaania, kehäkukkauutetta, tyrnimarjauutetta, fermentoitua Lactobacillus-uutetta, hyaluronihappoa, arginiinia ja kaurauutetta. Vaikutuksiltaan Calendula Glow -seerumi on kosteuttava, rauhoittava, kirkastava ja happiradikaaleilta suojaava. Seerumi tukee monivaikutteisesti ihon normaalia toimintaa ja sopii kaikille ihotyypeille. Koostumus on geelifluidimainen.
Vinkki: Frantsilan Calendula-seerumi sekä -puhdistusöljy ovat parhaillaan -20% tarjouksessa Frantsilan verkkokaupassa.

Päivän antioksidantti: FLOROTANNIINI
Florotanniini kuuluu polyfenolien antioksidanttiluokkaan, ja kolmosluukun astaksantiinin tavoin sitä esiintyy levissä (ja vain levissä, tarkemmin sanottuna ruskolevissä).
Florotanniini on erinomainen vapaiden radikaalien sieppaaja, mutta sillä on myös erityisominaisuus: se absorboi UVB-säteitä. Ei siis pelkästään neutraloi UV-säteilyn aikaansaamia happiradikaaleja, vaan neutraloi itse ultraviolettisäteilyä UVB-aaltojen pituuksilla.
Levät ovat aika velhoja mitä tulee suojautumiseen ympäristön rasitteilta: koska ne ovat erittäin alttiita stressaaville ympäristöolosuhteille kuten auringonvalolle, kuivumiselle (vuorovesialueet) ja suolavedelle, niiden on ollut pakko kehittää tehokkaita suojamekanismeja ehkäisemään tätä stressiä. Levissä onkin jopa 10-kertainen määrä erilaisia suojaavia sekä kosteutta ylläpitäviä yhdisteitä verrattuna maassa kasvaviin kasveihin. Kosmetiikkatiede on sitten valjastanut levien tuottamia molekyylejä myös ihmisihon hyödyksi. 🔬🧪
Florotanniinia ei käytetä kosmetiikassa eristettynä molekyylinä, vaan se tulee ihonhoitotuotteessa aina ruskoleväuutteen mukana. Kaikki ruskolevät sisältävät florotanniinia.

Florotanniinin ihohyötyjä:
1. Voimakas happiradikaalien sieppaaja.
2. Suojaa ihoa UVB-säteilyltä. (Mutta ei korvaa aurinkovoidetta.)
3. Hillitsee melaniinisynteesiä, minkä kautta vähentää liikapigmentaatiota ja tasoittaa ihon sävyä.
4. Suojaa kollageenia ja elastiinia estämällä MMP-entsyymien (metalloproteinaasit) toimintaa. MMP:t hajottavat kollageenia ja elastiinia.
5. Vähentää tulehdusta hillitsemällä tulehduksen välittäjäaineisiin kuuluvaa typpioksidia.

Tuotteen on lahjoittanut: Twistbe
Arvonta sulkeutunut. Luukun voittaja on nimimerkki Hanna.
Virolainen By Mukk on erikoistunut levätuotteisiin, ja sarjan Calm Sea -seerumi ammentaa tehonsa aloe verasta, probioottisesta uutteesta sekä ruskolevästä nimeltä Pelvetia Canaliculata. Koostumus on kosteuttava, rauhoittava ja tulehdusta lievittävä – ja ruskolevän sisältämien yhdisteiden myötä myös ihoa kirkastava ja pro-age-vaikutteinen. (Ruskolevä muuten sisältää monia muitakin iholle hyödyllisiä yhdisteitä kuin florotanniinin. 💎)
Calm Sea -seerumi tuo hyötyä ihan kaikille ihotyypeille kuivasta ihosta reaktiiviseen, ikääntyneeseen ja akneihoon. Sen voi sanoa sopivan ihan kaikille.

Päivän antioksidantti: C-vitamiini ja sen bestikset
Tässä luukussa tapaamme yhden monista kosmetiikan hyödyntämistä C-vitamiini-johdannaisista, ja tutustutan teidät myös C-vitamiinin bestiksiin. C-vitamiinin muodosta riippumatta, se on antioksidanttina tehokkaimmillaan, kun saa seurakseen E-vitamiinin ja ferulahapon. Lyhyt selitys: nämä kolme toimivat synergisesti toisiaan vahvistaen, ja kukin niistä on kavereidensa seurassa vahvempi antioksidantti, kuin yksinään. Friend power! 💖
Pidempi selitys: antioksidantti toimii luovuttamalla vapaalle radikaalille (pahismolekyylille) yhden elektroneistaan, minkä jälkeen siitä itsestään tulee radikaali (tosin stabiili sellainen), eikä se enää voi jatkaa työtään. Jotkut antioksidantit kuitenkin pystyvät uudistamaan toisiaan, jolloin elektroninsa luovuttanut antioksidantti voi palata töihin. C-vitamiini on E-vitamiinille tällainen kaveri; kun E-vitamiini on menettänyt elektroninsa ja hapettunut, C-vitamiini antaa sille uuden elektronin tilalle, jolloin E-vitamiini palaa aktiiviseen antioksidanttirooliinsa to kick some free radicals’ asses!
Ferulahappo puolestaan vahvistaa sekä C- että E-vitamiinin valonsuojatehoa ja vakauttaa erityisesti C-vitamiinia, joka tunnetusti on herkkä hapettumaan etenkin vesiympäristössä. Kun C-vitamiini-ihonhoitotuotteeseen lisätään ferulahappoa, se auttaa C-vitamiinia säilymään vakaana ja tehokkaana, jotta C-vitamiini on lopulta iholle päästessään mahdollisimman ”kovassa kunnossa”. 💪

C-vitamiini, & E-vitamiini & ferulahappo -yhdistelmän hyödyt iholle:
1. Laajan kirjon antioksidanttisuoja: vesiliukoinen C-vitamiini neutraloi vesiliukoisia vapaita radikaaleja, rasvaliukoinen E-vitamiini rasvaliukoisia, ferulahappo kumpiakin.
2. Tehokas suoja UV-säteilyn haittavaikutuksia vastaan: C-vitamiini suojaa ihoa erityisesti UV-säteilyn muodostamilta happiradikaaleilta, ferulahappo puolestaan kykenee absorboimaan UV-säteilyä.
3. Vahva solukalvojen suoja: sekä E-vitamiini että ferulahappo toimivat ihon suojakerroksessa ja suojaavat solukalvojen lipidejä hapettumiselta.
4.Ihon kirkastaminen: C-vitamiini kirkastaa ihoa ja hillitsee liikapigmentaatiota.

Siinä missä kosmetiikan E-vitamiini on lähes aina tokoferolia (muitakin E-vitamiinin muotoja on olemassa), ja ferulahappo on aina ferulahappo, C-vitamiini-molekyylejä on monia erilaisia.
Yksi kaikkein suosituimmista on askorbyyliglukosidi, joka on C-vitamiinin ja sokerimolekyylin yhdistelmä. Askorbyyliglukosidi on erittäin stabiili sekä iholle hellävarainen, ja se on helppo formuloida myös vesipohjaan, mikä tekee siitä rakastetun C-vitamiini-vaihtoehdon kosmetiikan tuotekehittäjille. Askorbyyliglukosidi on tunnettu erityisesti ihoa kirkastavasta vaikutuksestaan, minkä lisäksi se voi myös aktivoida kollageenin tuotantoa muuttuessaan ihossa puhtaaksi C-vitamiiniksi.
Askorbyyliglukosidi on yksi niistä C-vitamiinijohdannaisista, jonka on todettu muuttuvan ihossa puhtaaksi C-vitamiiniksi. Se on osoittanut in vitro -kokeissa kaikki samat hyödyt, jotka myös puhtaalla C-vitamiinilla on; eli vahva antioksidanttisuoja, ihon kirkastaminen ja kollageenin tuotannon aktivointi. Verrattuna puhtaaseen C-vitamiiniin, askorbyyliglukosidin vaikutukset vain ovat hitaammat - eivätkä yhtä vankasti tieteen vahvistamia, kuin puhtaan C-vitamiinin.

Tuotteen on lahjoittanut: Transmeri
Arvonta sulkeutunut. Luukun voittaja on nimimerkki Hippunen.
Tämä upea emulsioseerumi on monilahjakkuus; se kosteuttaa, pehmentää ja kirkastaa ihoa, sekä tuo iholle laajan kirjon antioksidanttisuojan ehkäisten laajalla spektrillä ympäristörasitteiden haittavaikutuksia iholla. Yllä mainittujen antioksidanttien ohella Intense Glow Concentrate sisältää myös tyrniöljyä ja lakkauutetta, mikä tukee seerumin ihoa vahvistavaa ja ikääntymismuutoksia hidastavaa vaikutusta. Käytetty C-vitamiinimuoto on askorbyyliglukosidi.

Päivän antioksidantti: ASTAKSANTIINI
Tänään tapaamme toisen karotenoideihin kuuluvan antioksidantin, astaksantiinin. Jos et vielä tunne astaksantiinia, se kannattaa laittaa korvan taakse: se on nimittäin yksi luonnon voimakkaimmista antioksidanteista ja ylittää vapaiden radikaalien neutralointitehollaan C- ja E-vitamiinin moninkertaisesti.
Kuten beetakaroteeni, myös astaksantiini on voimakkaan punaoranssi pigmentti, ja pienikin pitoisuus tätä ainesosaa tuo ihonhoitotuotteeseen lohenpunaisen tai oranssihtavan sävyn.
Astaksantiinin ihohyötyjä:
1. Äärimmäisen voimakas antioksidanttisuoja: suojaa ihoa tehokkaasti hapettumisstressiltä ja hidastaa soluvaurioita.
2. Ehkäisee UV-säteilyn aikaansaamia vaurioita ja ihon ennenaikaista ikääntymistä.
3. Suojaamalla kollageenia ja soluja oksidatiiviselta stressiltä, astaksantiini auttaa parantamaan ihon kimmoisuutta, vähentämään juonteita ja kirkastamaan ihoa.
4. Hillitsee tulehdusta. Astaksantiini voi mm. vähentää punoitusta ja tulehdusta auringon oton jälkeen.

Astaksantiinia saadaan kosmetiikkateollisuuden käyttöön viherlevästä nimeltä Haematococcus Pluvialis. Levä tuottaa astaksantiinia suojatakseen itseään UV-säteilyltä ja muulta hapettavalta stressiltä. (Eikö ole muuten huikeaa, että ihmisen iho voi myös hyödyntää tämän saman astaksantiinin ominaisuuden? 🤩)
Astaksantiinia voidaan käyttää kosmetiikassa joko eristettynä molekyylinä (incinimi Astaxanthin) tai osana leväuutetta (incinimi Haematococcus Pluvialis Extract). Koska astaksantiini on niin tehokas neutraloimaan juuri UV-säteilyn aikaansaamaa hapettumisstressiä, sitä näkee usein aurinkovoiteissa. Jos olet bongannut aurinkovoiteestasi Haematococcus Pluvialiksen, tässä syy. ☺️

Tuotteen on lahjoittanut: Ayu Organics
Arvonta sulkeutunut. Luukun voittaja on nimimerkki Etusormi.
(Muuten: lupaan, että kalenterin arvonnoissa on muitakin tuotteita kuin öljyjä..!)
Päivän antioksidanttituote on ylellinen sekoitus elvyttäviä, uudistavia, antioksidanttisesti suojaavia ja ravitsevia kasviöljyjä ja -uutteita. Kotimaisen Ayu Organicsin Golden Root Nectar -öljy sopii ihanteellisesti ikääntyneen ihon hoitoon; se hidastaa ikääntymisen merkkejä, kiinteyttää ja tuo ihoon luonnollista hehkua.
Tähän upeaan, oranssinpunaiseen eliksiiriin on sekoiteltu ainutlaatuisen ravinteikas yhdistelmä viinirypäle- ja makadamiansiemenöljyä, parsakaalinsiemenöljyä, moringaöljyä, ruusujuuri-, alfalfa- ja mangostaniuutetta sekä astaksantiinia. Juuri astaksantiini tuo öljyyn sen kauniin värin.
Golden Root Nectarin hienostunut, ihastuttava tuoksu tulee mangostani-hedelmän uutteesta. Tuotteeseen ei ole lisätty erikseen hajusteita.

Päivän antioksidantti: KAMATSULEENI
Kamatsuleeni (Chamazulene) on voimakas antioksidantti ja tulehdusta ehkäisevä yhdiste, joka tunnetaan erityisesti sen kyvystä rauhoittaa ihoa tehokkaasti.
Kamatsuleeni on sävyltään sinistä ja sitä esiintyy erityisesti tietyissä asterikasvien heimoon kuuluvissa kasveissa kuten Matricaria-kamomillassa (kamomillasaunio), sinisessä pietaryrtissä (marokkolainen kamomilla; Blue Tansy), siankärsämössä ja koiruohossa.
Kamatsuleenia ei ole kasveissa sellaisenaan, vaan se muodostuu höyrytislauksen yhteydessä kamatsuleenin esiasteesta, matrisiinista. Kamatsuleenia sisältävätkin ennen kaikkea kasvien eteeriset öljyt, eivät muut uutteet.
Kansanlääkinnässä kamatsuleeni-pitoisia kasveja on käytetty hoitamaan tulehduksia ja pieniä ihovaurioita kuten haavoja. Modernissa kosmetiikassa kamatsuleenia hyödynnetään erityisesti herkän ja reaktiivisen ihon hoitotuotteissa rauhoittamaan ihoärtymystä.
Kamatsuleeni on väriltään kirkkaan sinistä ja jo pieni määrä värjää ihonhoitotuotteen sinertäväksi. Kamatsuleenia käytetään harvemmin eristettynä, vaan se tulee kosmetiikkaan käytännössä aina kasvin eteerisen öljyn muodossa.

Kuva pietaryrtistä: Wikimedia Commons
💙 Triviaa: lähes aina, kun näet ihonhoitotuotteen, joka on nimetty "Blue-sitä-tai-tätä", ja tuotteen sävy on sininen, se sisältää kamatsuleenia, ja lähes aina lähteenä on Blue Tansy eli sininen pietaryrtti.
Miksi juuri Blue Tansy? Koska muut kamatsuleenia sisältävät eteeriset öljyt kuten kamomillasaunio tai siankärsämö eivät ole kovin hyvän tuoksuisia, ja Blue Tansy taas on, joten sen mukana saa bonuksena upean, aromaterapeuttisen tuoksun. Blue Tansyn tuoksu on vaniljaisen aromaattinen, puuterinen ja kevyen makea.
Tunnistat kamatsuleeni-pitoisia aineita incistä nimillä:
Tanacetum Annuum Flower Oil - Blue Tansy ("marokon kamomilla")
Matricaria Recutita Flower Oil - kamomillasaunio ("saksan kamomilla")
Achillea Millefolium Oil - siankärsämö
Anthemis Nobilis tai Chamaemelum Nobile Flower Oil - jalosauramo ("rooman kamomilla" - sisältää paljon vähemmän kamatsuleenia, kuin saksankamomilla.)

Tuotteen on lahjoittanut: Twistbe
Arvonta sulkeutunut. Luukun voittaja on Anni H.
Earth Harborin Marina-kasvoöljy saa sinisen sävynsä Blue Tansy -öljystä, joka on kamomillasaunion ja siankärsämön ohella rikkain kasvikunnan lähde kamatsuleenille.
Marina-kasvoöljy sisältää kamelia-, vesimeloninsiemen-, mustikansiemen- ja ruusunmarjansiemenöljyjä sekä spirulinaa, joka sekin on erittäin antioksidanttinen ja sisältää mm. kiinnostavaa fykosyaniini-nimistä antioksidanttia. Myös fykosyaniini on väriltään sinertävää sekä ominaisuuksiltaan tulehdusta rauhoittava.
Marina Biome -kasvoöljy on ihotuntumaltaan kevyt ja vaikutuksiltaan kosteuttava, antioksidanttisesti suojaava, tasapainottava sekä rauhoittava. Se sopii kaikille ihotyypeille.

Päivän antioksidantti: BEETAKAROTEENI
Beetakaroteeni on karotenoideihin kuuluva voimakas antioksidantti, joka toimii elimistössä A-vitamiinin esiasteena.
Beetakaroteeni on myös oranssin sävyinen pigmentti, ja tätä ominaisuutta voidaan hyödyntää ihonhoitotuotteissa tuomaan iholle tervettä sävyä.
Beetakaroteenin ihohyötyjä:
1. Sisäinen aurinkosuoja: beetakaroteeni neutraloi UV-säteilyn aiheuttamia vapaita radikaaleja iholla. Se auttaa vähentämään auringon aiheuttamia vaurioita ja voi myös ehkäistä auringon polttamaa.
2. Antioksidanttisuoja: beetakaroteeni suojaa ihoa reaktiivisten happilajien aikaansaamalta hapettumisstressiltä (saasteet, tupakansavu, auringonvalo) hidastaen näin ennenaikaista ikääntymistä
3. Ihon korjaaminen ja uudistaminen: muuttuessaan ihossa A-vitamiiniksi beetakaroteeni tukee kollageenin muodostumista ja ihosolujen uusiutumista ja auttaa ylläpitämään ihon normaalia toimintaa.
Beetakaroteenia voidaan käyttää ihonhoitotuotteissa eristettynä (incinimi beta-carotene) tai kasviuutteen sisällä. Käytetyin beetakaroteenin lähde on porkkanauute eli porkkanamaseraatti. Maseraatti on uutemuoto, jossa aktiiviaine irrotetaan liuottamalla lähtöraaka-ainetta kuten porkkanaa öljypohjassa. Tämä toimii hyvin, kun halutaan irrottaa rasvaliukoisia yhdisteitä, joihin beetakaroteeni kuuluu.
Porkkanauute näkyy incissä muodossa pohjaöljy + Daucus Carota Sativa Root Extract. Uutoksen pohjaöljynä käytetään yleisesti auringonkukkaöljyä, mutta myös manteli-, seesami- ja oliiviöljy ovat yleisiä.
Muita beetakaroteeni-pitoisia kosmetiikan ainesosia ovat mm. lakka, tyrni ja ruusunmarja.

Tuotteen on lahjoittanut: Berner
Arvonta sulkeutunut. Luukun voittaja on Mia Mikkonen.
Tässä meillä on kaikkein klassisin beetakaroteeni-tuote! 🥕 Porkkanaöljy on yksinkertaisen tehokas tuote, jolla on moninaiset ihohyödyt. Pure Beautyn tuote sisältää vain kaksi ainesosaa: porkkanamaseraatin ja E-vitamiinia. Kuten yllä kerroin, maseraatti koostuu aina pohjaöljystä ja uutettavasta aineesta, eli tässä tapauksessa porkkanasta. Tuotteen inci on auringonkukkaöljy + porkkanan juuriuute + E-vitamiini.
Porkkanaöljy tuo iholle auringonkukkaöljyn ravitsevat ja beetakaroteenin antioksidanttiset sekä UV-säteilyn vaurioilta suojaavat hyödyt. E-vitamiini vahvistaa porkkanaöljyn antioksidanttista tehoa. Porkkanaöljy on fantastinen hoitotuote esimerkiksi kesäaikaan koko vartalolla. Aurinkovoiteen alla käytettynä se tukee aurinkovoiteen UV-filtterisysteemiä ja parantaa ihon suojaa UV-säteilyn haittavaikutuksia vastaan. Auringonoton jälkeen käytettynä se auttaa ihoa palautumaan kosteuttaen ja täydentäen ihon lipidivarastoa. Beetakaroteenin pigmentti korostaa päivetystä.
***

Tänä vuonna joulukalenterin teema on:
antioksidantit ihonhoidossa
Tästä kosmetiikan ainesosaryhmästä on muodostunut minulle todellinen intohimo. Antioksidanttien kirjo on niin laaja, että ne ovat kosmetiikan ainesosanörtille kuin karkkilaari, josta löytää aina jonkin uuden, houkuttavan herkun. 🥰🍬
Antioksidantit eivät pelkästään suojaa ihosoluja vapaiden radikaalien ja reaktiivisten happilajien aiheuttamalta vauriolta (ja ennenaikaiselta ikääntymiseltä), niiden joukossa on myös anti-inflammatorisia eli tulehdusta rauhoittavia, ihon sävyä kirkastavia eli liikapigmentaatiota hillitseviä sekä kollageenin tuotantoa aktivoivia ja ihoa korjaavia molekyylejä. 🔥 Eikä unohdeta UV-säteilyä absorboivia antioksidantteja..! 🤩
Joulukalenterini on aina epäkaupallinen, eli arvonnat eivät ole kaupallisia mainosyhteistöitä. Olen valinnut tuotteet itse ja ottanut yhteyttä tuotetta maahantuovaan, valmistavaan tai myyvään tahoon ja pyytänyt saada tuotteen joulukalenterini luukkuun. 🙂
Tervetuloa seuraamaan joulukalenteriani. ☺️ Toivon, että se tuo teille iloa ja myös informaatiota, jota voitte hyödyntää omassa ihonhoidossanne.
Kalenterin luukut avautuvat tässä samassa postauksessa, ja uusin luukku näkyy ylimpänä. Kunkin luukun arvontaan voi osallistua luukun avautumisesta seuraavaan päivään klo 9.00 saakka.
Välitän lämpimän kiitoksen kalenteriini osallistuville yrityksille, lahjoituksenne tuovat paljon iloa! ❤️

278 comments on “Joulukalenteri 2025”
Olipa ihana joulukalenteri :) Rauhallista joulua ja onnellista seuraavaa vuotta!
Tämä on ihana.
Olis melkein pelottavaa, jos olisi näin hieno ja arvokas tuote käyttää. Sahramiakin käytän yleensä sormet vapisten, niin ainutlaatuiselta se tuntuu😂
Kivan näköinen pullo ,kelpaisi olla esillä ,sisältääkin vaikuttaa hyvältä 👌🏻
Hep
Kiitos joulukalenterista ja ihanaa joulua! 🎄
Mukana!
Vau tästä antioksidantista en ole ennen kuullutkaan! 🤩
Kiitos mielenkiintoisesta joulukalenterista ja hyvää joulua! 🥰
Hyvää joulua ja onnellista vuotta 2026 Sanni:)
Nyt on ihanan ylellinen tuote 🤩
Oikein ihanaa joulua Sanni ja kiitos tästä blogista.
Mukana arvonnassa! 😊
Hyvää joulua Sanni ja kiitos tästä opettavaisesta kalenterista 🥰
Mukana
Äärimmäisen kiintoisa antioksidantti. Myös palkintona oleva seerumi kiinnostaa, onkohan sitä vaikea löytää kaupoista?
Aivan ihana joulukalenteri ollut tänä vuonna! 🎄
Ihana tuote ja upea joulukalenteri sinulla.
Hyvää joulua🎄 Olen oppinut kauttasi paljon uutta tämän vuoden aikana 🥰
Tää kalenteri oli kyllä huippu, kiitos tästä! Oikein mukavaa joulunaikaa 🎄
Tästä tuotteesta en ole aiemmin kuullutkaan. Vaikuttaa mielenkiintoiselta
Mukana🎄🎄
Rauhallista joulua kaikille!
Olis varnaan ihana tuote✨ Mukana.
Korres on vielä tuntematonta kosmetiikkaa minulle. Mukana arvonnassa!
Kiitos informatiivisesta joulukalenterista ja hyvää joulua!
Mukana :)
Ihanan juhlava tuote. Hyvää joulua!
Mukana
Kiitos ihanasta joulukalenterista!!
Mahtava tuote! Hyvää Joulua.
Mukana arvonnassa! Hyvää joulua!
Mukana! 🧑🏻🎄🎄🎁
Kivan oloinen tuote ja tämä joulukalenteri oli tosi monipuolinen infopläjäys! Kiitos ja hyvää joulua
Mukana 24! Hyvää Joulua!
Mukana taas! Hyvää jouluaattoaamua ja rauhallista joulun viettoa!
Ihanaa joulua Sanni ja kiitos tästä mahtavasta joulukalenterista josta sai oppia joka päivä jotain uutta 🎄🕯️🎁
Mukana!
Wau 😍
Tämä oli täysin uusi antioksidantti
Kiitos joulukalenterista ja hyvää joulua!
Siis apua, mikä tuote! Tässä postauksessa oli kaikki uutta. Hyvää joulua.
Hyvää Joulua!
Hyvää joulua! Mukana arvonnassa♡
Hyvää joulua! Mukana arvonnassa♡
Oi, tämä on ihan uusi tuote mulle korresilta 😍 ois mahtava testata.
Tää ois huippu!
Mukana minäkin
Hyvää joulua!
Mukana!
Tää olis äitille 🪷
Kiitos kalenterista ja rentoa joulun aikaa! ⛄
Rauhallista Joulua!
Ihanaa joulua 🥰
Ihana tuote! Hyvää joulua kaikille!
Ylelliseltä vaikuttava tuote.
Onkin tovi kun olen viimeksi käyttänyt Korresin tuotteita.
Iloista joulumieltä!
Aivan ihana tuote! Hyvää joulua kaikille!
Hyvää joulua :)
Oi mikä tuote! Tämä olisi ihana antaa lahjaksi omalle äidille!
Ihana blogi,suosikkini! Tätä kautta löysin juuri esim. Korresin tuotteet ja Visbyn parhaat paikat. Hyvää joulua!
Sanni, ihan mahtavaa kun nostat esille meille näitä mahtavia tuotteita!
Kaunis kiitos sinulle!
Kiinnostaa!
Mielenkiintoinen tuote! Mukana arvonnassa ❤️🤗
Hyvää joulua
Hyvää joulua! Kiitos tästä upeasta joulukalenterista <3
Kiitos Sanni tästä ihanasta joulukalenterista. Tuli tosi paljon uutta ja mielenkiintoista tietoa taas. Oot paras! ❤️
Hyvää joulua kaikille, ketkä sattuvat kommenttini lukemaan! 💖🎄
Ihana blogi! Mukana jouluaaton arvonnassa ☺️
Hyvää joulua! ❤️
Hyvää joulua ❤️
Haittaako kaurauute kosmetiikassa, jos on ihokeliakia
Hyvää Joulua
Näen mielessäni krokotiilin korkokengissään. On helmet kaulassa, käsiväsky ja röyhelöinen kukkahattukin.
Hyvää joulua ja kiitos tästä kalenterista!
Mukana <3 Hyvää joulua!
Hyvää Joulua! ☃️
💜🍇💜
Yes please! Hyvää joulua ❤️
Haluisin
Hyvää joulua 🎄
Iso kiitos tämän vuoden joulukalenterista, olet todella panostanut siihen. On ollut ilo lukea ja saada todella paljon uutta mielenkiintoista tietoa. Hyvää joulun aikaa ja onnellista uutta vuotta!
Rauhallista Joulua kaikille lukijoille =) ja suurkiitokset Sannille työstään bloginlukijoiden informoijana ja ajatuksiensa jakajana!
Kiitos tästä kalenterista. Toivottavasti onni suosii mua.
Ihanaa joulua! ✨
Wau tuote, mukana!
Mukana
Hyvää joulua! 🎄
Hyvää joulua!
Tätä Korressin ylellistä seerumia olisi ihana päästä testaamaan omalle iholle ✨
Kiitos mahtavasta joulukalenterista ja hyvää joulua sinulle 🌲💚
Hyvää joulua! 🎄
Ihana joulukalenteri, kiitos siitä. Ja oikein lämmintä joulunaikaa perheesi parissa🥰
Ihanaa joulua 😊
Toivottavasti onni suosii ❤️
Tuote tulisi tarpeeseen
Ihanan ylellinen tuote!💜💜💜Kiitos kattavasta joulukalenterista🙏Paljon tuli taas opittua😍
Tuote on minulle uusi, toivottavasti pääsisin testaamaan 😊
Kuulostaapa ihanalle tuotteelle! Hyvää joulua!
Mukana arvonnassa :) Kiitos tästä joulukalenterista, tämä oli kiva sekoitus tietoa ja viihdettä arvonnan muodossa. Hyvää joulua :)
Kuulostaa mielenkiintoiselta tuotteelta 😊
Hyvää joulua! ☺️🎄
Tämä joulukalenteri on ollut ihan huippu!
Ihanaa joulua🎄
😍
Hyvää Joulua😊
Ihanaa joulua Sanni! Ja kiitos jälleen vuodesta Karkkipäivää 🥰⭐️
Korres best ❤️